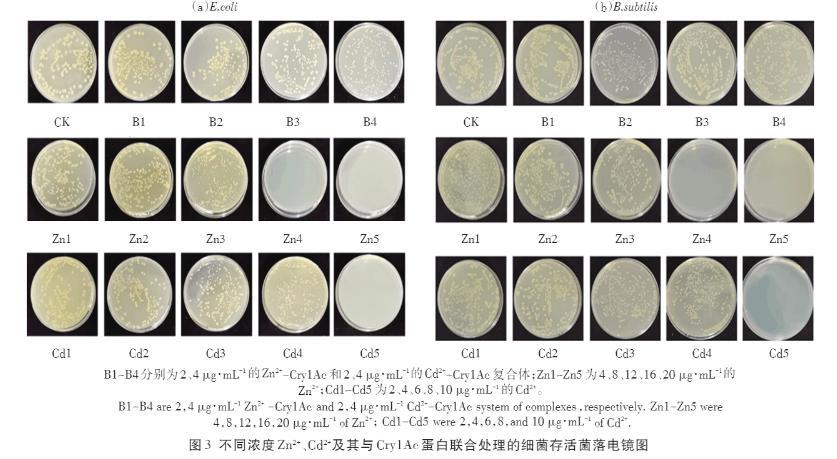

Zn2+、Cd2+、Cry1Ac蛋白單獨及聯合暴露對大腸桿菌和枯草芽孢桿菌的毒性作用(二)
1.2.4急性毒性實驗
在超凈無菌工作臺內將-20℃保存的Vibrio fisch?eri凍干粉西林瓶打開,取復蘇液1 mL于室溫下平衡復蘇10 min,振蕩搖勻。吸取發光菌液1 mL,用2%NaCl稀釋至40 mL。將不同濃度樣品(Zn2+、Cd2+、Cry1Ac蛋白和復合體系)溶液放在96孔板中,不同物質每個濃度設置3個平行,第一行設置為陰性質控(2%NaCl),為初始發光強度,第二行為陽性質控(10 mg?L-1的ZnSO4溶液),為樣品發光強度。各孔中加入樣品液180μL和發光菌液20μL,總體積200μL,15 min后放入檢測儀測定發光強度。根據Vibrio fischeri的熒光強度計算抑制率(RI,%),計算公式如下:
R1=(C0-St)/C0*100%
式中:C0為陰性質控初始發光強度;St為t時樣品的發光強度。
1.3數據處理
每個實驗設置3個重復,采用SPSS 22進行分析,采用單因素方差分析(ANOVA)和最小顯著性差異(LSD)檢驗差異的顯著性,采用Origin 9繪圖。
2結果與討論
2.1不同濃度Zn2+、Cd2+對細菌生長曲線的影響
重金屬對細菌生長會產生抑制作用,濃度愈高抑制作用愈強。Zn2+、Cd2+濃度增加對B.subtilis和E.coli的抑制增強(圖1),E.coli細胞壁具有帶負電荷的脂多糖,其可與更多的金屬陽離子結合,B.subtilis耐性強于E.coli。不同金屬對生物體的毒性不同,Cd2+對B.subtilis和E.coli生長的抑制作用大于Zn2+。Cd是強毒性元素,低濃度就有很強的毒性;Zn是生物體必需元素,低濃度Zn可保護細胞免受傷害。Zn2+和Cd2+的加入均對兩種細菌產生了不同程度的毒害,如圖1所示,Cd2+對兩種細菌的生長抑制效果強于Zn2+。不同濃度的Zn2+和Cd2+脅迫培養細菌生長0~24 h時,OD值均低于對照組。隨著金屬濃度的增加,0~11 h為B.subtilis的生長期,此時生長曲線呈快速生長趨勢,吸光值增大,12~15 h處于穩定期,15 h以后OD值減弱,此時為衰亡期。Zn2+和Cd2+濃度分別在20μg?mL-1和8μg?mL-1時完全抑制E.coli生長。

圖1不同濃度Zn2+、Cd2+對細菌生長曲線的影響
2.2 Cry1Ac蛋白及其與Zn2+、Cd2+聯合暴露對細菌生長曲線的影響

圖2為Cry1Ac蛋白及其與Zn2+、Cd2+聯合暴露條件下的細菌生長曲線。
在0~16 h,各處理組細菌生長曲線的OD600值均低于對照組。在0~10 h內細菌處于生長期,Cry1Ac蛋白和Zn2+-Cry1Ac、Cd2+-Cry1Ac聯合暴露對B.subtilis和E.coli生長產生抑制,且隨濃度增加細菌生長受到的抑制作用增強,且E.coli比B.subtilis更為敏感。Cd2+單獨及復合體系對兩種細菌的毒性明顯強于Zn2+單獨及其復合體系,Zn在短期內的毒性可能與生物體內貯存濃度有關,當Zn在生物體內積累到一定濃度就會啟動金屬硫蛋白,促使其與金屬硫蛋白結合而降低毒性。同時Zn2+和Cd2+都會與Cry1Ac蛋白結合,從而減輕重金屬對細菌的毒害。
2.3 Cry1Ac蛋白及其與Zn2+、Cd2+聯合暴露下菌落平板生長狀況觀察
采用平板計數法檢測Zn2+、Cd2+及Cry1Ac蛋白聯合暴露時對E.coli和B.subtilis存活的影響,結果如圖3所示。隨著重金屬濃度的增加,細菌的存活率顯著降低(P<0.05)。重金屬會抑制細菌酶活性及其生長,高濃度重金屬甚至會導致細菌死亡。Cd2+濃度為10μg?mL-1時E.coli和B.subtilis的存活率均為0,表明Cd2+濃度為10μg?mL-1時對兩種細菌的抑制率達到最大。當Zn2+濃度為16μg?mL-1時,E.coli的存活率為0,Zn2+濃度為20μg?mL-1時,B.subtilis的存活率為0,表明Zn2+濃度為16、20μg?mL-1時分別對兩種細菌抑制率達到最大。當Zn2+-Cry1Ac的濃度為4μg?mL-1時,對E.coli和B.subtilis的存活率分別為74.7%和76.8%,當Cd2+-Cry1Ac濃度為4μg?mL-1時,E.coli和B.subtilis的存活率分別為66.1%和71.2%,即Cd2+-Cry1Ac對兩種細菌生長的抑制效果強于Zn2+-Cry1Ac。
圖3不同濃度Zn2+、Cd2+及其與Cry1Ac蛋白聯合處理的細菌存活菌落電鏡圖
